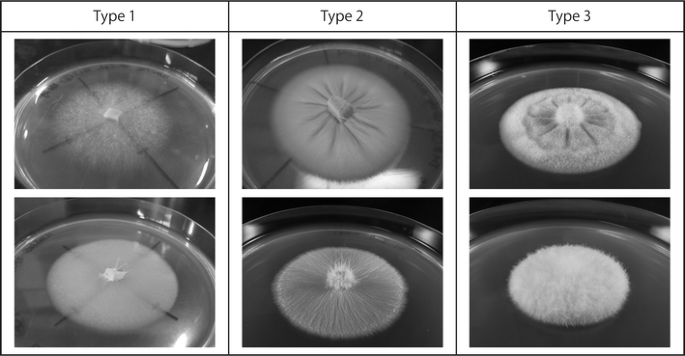
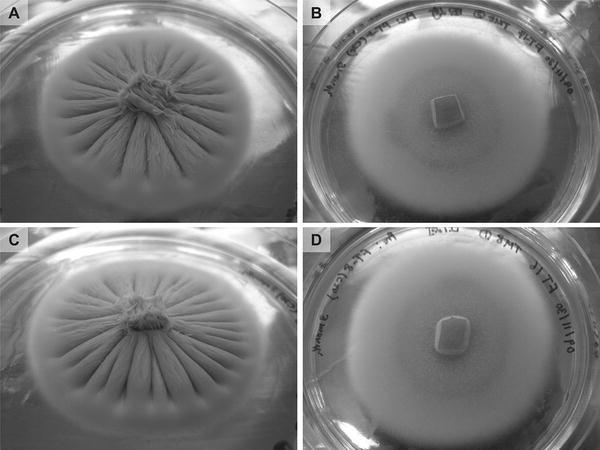
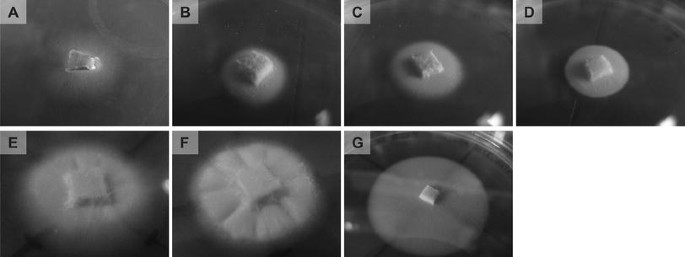

- Original article
- Published:
Zn2+, a key factor of colony morphogenesis of Tricholoma matsutake
Journal of Wood Science volume 62, pages 460–471 (2016)
Abstract
Tricholoma matsutake is a basidiomycete producing edible fruiting bodies known as matsutake in Japanese. Matsutake is one of the most valuable edible mushrooms in Japan. Colony morphology on agar plates of T. matsutake is known to vary depending on compositions of media used, while the mechanism is still unknown. In our present work, we have found Zn2+ affects colony morphology of T. matsutake. When Zn2+ was added at concentration more than 1 µM, colony got wrinkled and aerial hyphae formation was activated. No such morphological changes have been confirmed without Zn2+ addition or at concentration less than 1 µM, even when other nutritional ingredients are provided sufficiently. None of the Zn2+ concentrations examined present has affected colony diameter, dry weight, and water content. These findings imply Zn2+ is a key factor involved in colony morphogenesis of T. matsutake such as colony wrinkling and aerial hyphae formation. Metabolomic information obtained with gas chromatography–mass spectrometry has indicated that Zn2+ deficiency has influences on carbohydrate and l-serine metabolisms.
Introduction
Fungi have a variety of morphologies from microscopic to macroscopic, and they transform in response to various stimuli from surroundings. One of the stimuli is an ingredient of culture media. In this paper, we report Zn2+ in culture media works as a key factor of vegetative colony morphogenesis in Tricholoma matsutake (S. Ito et Imai) Singer.
T. matsutake is an ectomycorrhizal basidiomycete, the fruiting body of which is known as matsutake in Japanese. Its flavor has been fascinating the Japanese since ancient times; therefore, matsutake is one of the most valuable edible mushrooms in Japan like a truffle in Europe. Matsutake has yet to be cultivated artificially, while major edible mushrooms can be harvested from mushroom beds now. Researchers have been trying to build fruiting bodies of T. matsutake in vitro for more than 50 years, from the aspects of vegetative growth [1–4] and enzymatic activity [5]. Within those studies, several colony morphologies have been observed, however, little have been discussed the factors inducing the morphogenesis. Ogawa has estimated that some organic nutrients would give morphological differences to T. matsutake colony in his book [6]. On the other hand, relevance of metal ions and fungal colony morphologies has been reported using two fungal species Rhizopus arrhizus Fischer and Trichoderma viride Pers [7].
Our present work was carried out to find factors involved in colony morphogenesis widely observed in T. matsutake, that is, colony wrinkling and aerial hyphae formation. First of all, we performed a screening of the factors. As the result indicated relevance of Zn2+, we examined an effective concentration of Zn2+ to induce colony morphological changes. We also carried out gas chromatography–mass spectrometry (GC/MS) analysis of methanol extracts of T. matsutake mycelia cultured on the synthesized media with or without Zn2+ addition, to examine the influence of Zn2+ deficiency on metabolic profile of T. matsutake and speculate candidates of metabolic pathway involved in the phenomena observed in present.
Materials and methods
Culture media preparation
All the culture media in Tables 1 and 3 were prepared with special grade chemicals and ultrapure water (18.2 MΩ cm). Those basal media compositions were decided referring to Murashige and Skoog medium [9], Modified Melin Norkrans medium [10], and Ohta agar medium [8]. Disposable petri dishes (∅ = 9 cm) were used for present experiments. Media not containing Zn2+ were prepared without adding ZnSO4·7H2O, certainly containing impurities levels of Zn2+ of other reagents. All of them were sterilized by autoclaving at 121 °C for 15 min. Carbon sources and amino acids were autoclaved separately to avoid Maillard reaction.
Fungal strains
Fungal strains of T. matsutake used in present work were TM3 (NBRC 109050), TM8 (NBRC 109051), and TM19 (NBRC 109052).
Screening process for a factor of colony morphological changes
Largely three types of colony morphology are known in T. matsutake; (1) flat circular form with or without tiny aerial hyphae, (2) wrinkled and flat circular form with or without a few bold aerial hyphae, and (3) wrinkled and flat circular form with a lot of fine aerial hyphae (Fig. 1).
Colony morphological types observed in T. matsutake when cultured on agar plates. Type 1 flat circular form with or without tiny aerial hyphae, type 2 wrinkled and flat circular form with or without a few bold aerial hyphae, type 3 wrinkled and flat circular form with a lot of fine aerial hyphae. Two photographs in each of the types indicate examples of colony morphologies
We considered minor metal ions as the candidates of factors inducing colony morphology mentioned above by comparing media ingredients of several synthesized media and colony morphology cultured on those media. To determine a metal ion involved in the morphogenesis, morphologies of colonies cultured on synthesized media with different metal ion compositions, Nos. 2–5 (Tables 1, 2), were compared. In this experiment, strain TM8 was used. It had been precultured on the medium No. 1 at 25 °C for 3 months in darkness. 5 mm square of the mycelium was taken from the edge of precultured one. The fragment was inoculated onto the media Nos. 2–5, and incubated at 25 °C for 2 months; then, colonies were observed. Each experiment consisted of 3 replicates.
Confirmation of the effect of Zn2+ on colony morphological changes
To confirm that Zn2+ is a factor of the colony morphogenesis, three strains, TM3, TM8, and TM19, were cultured on Ohta agar medium (Table 1, [8]) and Zn2+-not added one (Ohta_zNA). 5 mm square of mycelial fragment was taken from the edge of the colonies precultured on the medium No. 6 (Table 1) at 25 °C for 2 months, inoculated onto Ohta agar and Ohta_zNA media, and incubated at 25 °C for 40 days. This experiment was carried out with each 3 replicates.
The influence of folic acid and nicotinic acid on Zn2+-induced colony morphogenesis
A 7 mm square of mycelial fragment was cut out from each colony of TM3 and TM8 precultured on a medium No. 9 (Table 3) for 2 months at 25 °C. The fragments were inoculated on media Nos. 9–15, and incubated for around 1 month at 25 °C. After incubation, their colony morphologies were observed. Concentrations of Zn2+, folic acid, and nicotinic acid in those media, and colony morphologies on each media are described in Table 4.
Effective concentration of Zn2+ to induce colony morphological changes
Fungal strains used and test media preparation
In this experiment, strains TM3, TM8, and TM19 were used. A basal test medium was No. 8 in Table 1. Examined concentrations of Zn2+ were 0 (without Zn2+ addition), 0.01, 0.1, 1, 10, 100 µM. They were prepared by adding 1 or 100 mM of ZnSO4·7H2O aqueous solutions. 1 mM solution was used for preparing media with 0.01, 0.1, and 1 µM of Zn2+, and 100 mM one was for 10 and 100 µM.
Fungal colony biomass measurement and water content calculation
To remove colonies easily, dry-heat sterilized cellophane membrane (6 cm square, TEFCO Co., Ltd.) was laid on each test medium prior to inoculation. A 5 mm in diameter of mycelial disk was stamped out with a cork borer from the colonies precultured on the medium No. 7 (Table 1) at 23 °C for 200 days, and then inoculated onto the center of the cellophane membrane-laid medium. After 2-month incubation at 23 °C, each colony was removed from the cellophane membrane, weighed, wrapped in dry weight-known aluminum foil, and dried at 70 °C for 3 days in an electric oven. Dried foil-wrapped colonies were cooled in a desiccator and weighed. Colony dry weight was calculated by subtracting dry weight of aluminum foil from that of foil-wrapped colony.
Water content was calculated by the following formula.
These experiments were carried out with each 5 replicates.
Colony diameter measurement and morphology observation
Another 6 replicates of each test medium were prepared for colony diameter measurement and morphology observation. Cellophane membrane was not used in this experiment. Fungal inoculation and culture were the same as mentioned in the section of “Fungal colony biomass measurement and water content calculation”. After 2-month culture, colony diameters were measured in two directions crossed at a right angle. All the colonies were photographed from right above and the lateral side.
GC/MS analysis
Fungal sample preparation
Medium No. 8 (Table 1, without Zn2+ addition) and No. 8 with 10 µM of Zn2+ addition (No. 8_z) were, respectively, prepared in twenty-four disposable petri dishes of 9 cm in diameter. A sheet of dry-heat sterilized cellophane membrane was laid on each test media as mentioned in the section of “Fungal colony biomass measurement and water content calculation”. A 5 mm in diameter of mycelial disk was stamped out from a precultured T. matsutake strain TM19 with a cork borer, and it was inoculated on the center of the each media. The preculture medium was a glucose-yeast extract medium containing 2 % of glucose and 0.2 % of yeast extract solidified with 1.5 % agar. Inoculated fungi were incubated at 23 °C in darkness for a month. Those fungi were removed from the cellophane membrane. Among 24 samples of each test group, every 8 colony was frozen together with liquid nitrogen and ground in a mortar, except a part of inoculated disk. Those three sets of ground mycelia were then lyophilized immediately.
Metabolome extraction
About 30 mg of lyophilized mycelial powder was taken from each three set of both test groups, and put them into 2.0 ml polypropylene conical tube; detailed amounts of each mycelial powder were 30.10, 29.82, 30.79 mg from the group of medium No. 8_z, and 30.38, 29.98, 30.13 mg from that of medium No. 8. A thousand micro litter of cold methanol (−30 °C) containing 20 ppm of ribitol as an internal standard was added into each mycelial powder, and stirred at 1500 rpm for 1 min with a tube mixer (CM-1000, Biomedical Science Co., Ltd., Tokyo, Japan). They were centrifuged at −5 °C, 13,000×g for 20 min, and each of the supernatant was collected in a 1.5 ml glass conical tube. Five hundred micro litter of the cold methanol was added into each of the residues, and the same extraction procedure was performed. The collected supernatants were centrifugal evaporated at 55 °C, and then chemical derivatization was proceeded. The derivatization procedure consisted of methoximation (50 µl of methoxyamine hydrochloride dissolved in pyridine at 20 mg/ml) and trimethylsilylation (100 µl of MSTFA, N-acetyl-N-(trimethylsilyl)-trifluoroacetamide, with 1 % TMCS, chlorotrimethylsilane). The former procedure was performed at room temperature for 60 min, being stirred at 1500 rpm, and the latter was done at room temperature for 3.5 h, being stirred at 1200 rpm.
GC/MS analytical condition
GC/MS analysis was performed with Agilent 7890GC/5975MSD. Agilent HP-5 ms column was used (0.25 mm I.D. × 30 m, df = 0.25 µm). Sample injection volume was 1 µl. Other settings were as shown in Table 5. Identification of metabolite peaks of interest was performed by mass spectral library search using NIST08 (mass spectral match >90 %). Peaks of carbohydrates, which have many candidates of structural isomers with the same spectral match, were identified by retention time of those chemical standards analyzed by the same GC/MS analytical condition.
Statistical analysis
Differences in mean values of colony diameter and dry weight were assessed with Scheffe’s F test, and those of peak area ratios of metabolites per peak area of internal standard, acquired by GC/MS analysis, were evaluated with Student’s t test. Both statistical analyses were performed using Statcel version 2 (OMS Ltd.) on Microsoft Excel for Mac 2011.
Results
Factors of colony morphological changes
Shown in Fig. 2 are photographs of the colony morphologies when cultured on the media with different minor metal composition. Colony grew flat and sparse when cultured on the media without Zn2+ addition (Fig. 2b, d). From this result, we considered Zn2+ is essential for wrinkled colony morphology.
To confirm the hypothesis, Ohta agar medium, a synthesized medium used for culturing mycorrhizal fungi, and Ohta_zNA (zNA: without Zn2+ addition) medium were used for culture test. Colony morphologies of the strains TM3, TM8, and TM19 cultured on those media for 40 days are shown in Fig. 3. Colonies of TM3 and TM8 on Ohta agar medium got wrinkled, and fine aerial hyphae covered on the surface. They were elastic like rubber and difficult to be stamped out by a cork borer. Colony of TM19 on Ohta agar medium formed a lot of fine aerial hyphae on the wrinkled colony surface. On the other hand, no wrinkled form and active aerial hyphae formation were confirmed on Ohta_zNA medium in all the strains used, and the colonies were easily stamped out with a cork borer. Thus Zn2+ can be considered as a key factor to give toughness, wrinkled form, and active aerial hyphae formation to the colony of T. matsutake.
Colony morphologies of T. matsutake strains TM3 (NBRC 109050), TM8 (NBRC 109051), and TM19 (NBRC 109052) cultured on Ohta agar and Ohta_zNA (without Zn2+ addition) media. a–c TM3, TM8, and TM19 cultured on Ohta agar medium respectively. d–f TM3, TM8, and TM19 cultured on Ohta_zNA medium respectively
Shown in Figs. 4 and 5 are colony morphologies of the strains TM3 and 8 cultured on the media with different compositions of Zn2+, folic acid, and nicotinic acid (medium Nos. 9–15 in Table 3). When cultured on 0.35 µM of Zn2+ without both folic acid and nicotinic acid, colonies got flat and sparse, and transparent enough to see its background (Figs. 4a, 5a). When given 17.5 µM of Zn2+ without both folic acid and nicotinic acid or 0.35 µM of Zn2+ with folic acid or nicotinic acid, they got flat and dense (Figs. 4b–d, 5b–d). Furthermore, when supplied 17.5 µM of Zn2+ with folic acid or nicotinic acid, colonies got wrinkled (Figs. 4e, f, 5e, f). Without Zn2+, colonies remained flat and sparse even when both folic acid and nicotinic acid were provided (Figs. 4g, 5g).
Effective concentration of Zn2+ to induce colony morphological changes
Shown in Fig. 6 are photographs of colonies of TM3 and TM19 cultured on synthesized media with 0–100 µM of Zn2+. Wrinkled colony was observed at 10 and 100 µM of Zn2+ in the strain TM3 (Fig. 6e, f), however, differences were not so clear. On the other hand, colony morphological changes of TM19 were apparent. Colony wrinkling and aerial hyphae formation were observed when cultured on the media with more than 1 µM of Zn2+ (Fig. 6j–l).
Colony morphologies of T. matsutake strains TM3 (NBRC 109050) and TM19 (NBRC 109052) cultured on a series of media No. 8 with different Zn2+ concentrations. a–f TM3 cultured at 0, 0.01, 0.1, 1, 10, and 100 µM of Zn2+ respectively. g–l TM19 cultured at the same Zn2+ concentration with TM3 respectively
The influence of Zn2+ on the growth of T. matsutake
Colony diameters when cultured at each Zn2+ concentration are shown in Fig. 7, and shown in Fig. 8 are colony dry weight and water content. Statistical significances are detected between bars or points of line graph with different alphabets (Scheffe’s F test, P < 0.05). Colony diameter of TM3 tended to get larger when cultured on the media with more than 1 µM of Zn2+, while that of TM19 had decreasing tendency. Colony dry weight and water content of TM3 did not so fluctuate by Zn2+ concentrations contrary to TM19.
Colony diameter of T. matsutake strains TM3 (NBRC 109050) and TM19 (NBRC 109052) cultured on a series of media No. 8 with different Zn2+ concentrations. a TM3, b TM19. Values: mean ± SD (standard deviation), n = 6. Statistical significance evaluated by Scheffe’s F test is between bars with different alphabets (P < 0.05)
Colony dry weight and water content of T. matsutake strains TM3 (NBRC 109050) and TM19 (NBRC 109052) cultured on a series of media No. 8 with different Zn2+ concentrations. A line graph indicates water content, and a bar graph is of dry weight. a TM3, b TM19. Values: mean ± SD (standard deviation), n = 6. Statistical significance evaluated by Scheffe’s F test is between bars or points of the line graph with different alphabets (P < 0.05)
The influence of Zn2+ on metabolic profile
To discuss the colony morphological changes caused by Zn2+ deficiency in terms of metabolic pathways, we obtained metabolic profiles of T. matsutake mycelia cultured on media with or without Zn2+ addition, using GC/MS. The obtained chromatograms are shown in Fig. S1 (supplementary figure). Peak area ratios of six metabolites to that of internal standard (ribitol) were found to have statistically significant differences (P < 0.05). As shown in Table 6, they are l-serine (library spectral match: 95), glycerol-3-phosphate (library spectral match: 94), d-fructose (identified by the standard chemical: Wako 127-02765), d-glucose (identified by the standard chemical: Wako 049-31165), d-mannitol (identified by the standard chemical: Wako 133-00845), and d-trehalose (library spectral match: 94). l-Serine (P = 0.0005), d-fructose (P = 0.000001), d-glucose (P = 0.001), d-trehalose (P = 0.01) were detected with higher abundance in the sample of without Zn2+ addition than that of with Zn2+ addition. Glycerol-3-phosphate (P = 0.02) and d-mannitol (P = 0.0009) were detected more in the sample of with Zn2+ addition.
Discussion
In present work, we set out to determine a key factor regulating colony morphogenesis such as wrinkling and aerial hyphae formation of T. matsutake. As shown in Figs. 2 and 3, Zn2+ is apparently a key factor of such morphogenesis. Ohta agar medium is a synthesized one containing a variety of nutrients; minor and major metal elements, a diversity of vitamins, a nitrogen source, and a carbon source [8]. Even on this nutritionally rich medium, colony wrinkling and aerial hyphae formation did not occur just by not adding Zn2+ (Fig. 3). This also support that Zn2+ is a key substance to induce colony morphogenesis in T. matsutake.
In the experiment of effective concentration of Zn2+, using the medium No. 8 with a series of Zn2+ concentration, T. matsutake strain TM3 did not show a drastic colony morphological change as observed in TM19 (Fig. 6), whereas when using Ohta agar, in which nearly 10 µM of Zn2+ is included, apparently different colony morphologies from those observed on the medium No. 8 with 10 µM of Zn2+ addition were confirmed (Fig. 3). This difference in the extent of Zn2+ influence is believed to be due to synergistic effects with other nutrients. Some or one, organic or inorganic ingredients in Ohta agar medium can affect the influence of Zn2+. Present results of the influence of folic acid and nicotinic acid on colony morphologies can support the hypothesis (Figs. 4, 5).
Colony diameter, dry weight, and water content did not fluctuate depending on Zn2+ concentrations (Figs. 7, 8). Usual colony expansion speed of T. matsutake, when cultured under an optimum condition, is 1.0–1.5 cm a month, which supports the strains used in present study were not inhibited to grow by the applied concentrations of Zn2+. Thus Zn2+ can be considered to have an influence on morphogenesis, not on the growth evaluated by diameter, dry weight, and water content.
Present metabolomic data of methanol extract of T. matsutake mycelia cultured with or without Zn2+ addition has indicated that Zn2+ deficiency influences carbohydrate and l-serine metabolisms. Fructose-bisphosphate aldolase (E.C. 4.1.2.13), which catalyzes a reaction that converts fructose-1,6-bisphosphate into dihydroxyacetone phosphate and glycerol-3-phosphate (G3P), is known to have Zn2+ as a cofactor. Thus, smaller content of G3P in the mycelia cultured without Zn2+ addition (Table 6) may be caused by the inhibition of the enzyme. Biosynthesis of d-mannitol also seems to have been inhibited by Zn2+ deficiency (Table 6). One of the reactions of mannitol biosynthesis is catalyzed by NADP (nicotinamide adenine dinucleotide phosphate)-dependent mannitol dehydrogenase (E.C. 1.1.1.138) from d-fructose. Zn2+ is a cofactor of NADPH (reduced form of NADP) dehydrogenase (E.C. 1.6.5.2), thus inhibition of mannitol dehydrogenase due to lack of NADP caused by Zn2+ deficiency could lead smaller content of mannitol in the mycelia cultured without Zn2+ addition, and d-fructose accumulation in those cultured with Zn2+ addition (Table 6; Fig. 9). As for l-serine metabolism (Fig. 10), its accumulation under Zn2+ deficient condition can be caused by inhibition of pyridoxal kinase (E.C. 2.7.1.35), a cofactor of which is Zn2+. This enzyme catalyzes a conversion from pyridoxal into pyridoxal-5-phosphate (P5P). Most of the enzymes relating to serine metabolism are pyridoxal phosphate enzymes: E.C. 2.1.2.1, E.C. 2.6.1.45, E.C. 4.2.1.20, E.C. 4.2.1.22, and E.C. 4.3.1.17. Thus, we are speculating that inhibition of the metabolic pathways due to the insufficient supply of P5P has resulted in the accumulation of l-serine. As l-serine is a starting metabolite of cysteine and methionine metabolism, the inhibition of serine metabolism can also bring about lack of the sulfur containing amino acids. This will affect biosynthesis of proteins with disulfide bonds such as hydrophobins, which are reported to play an important role in building aerial structures of fungi [11, 12]. Folic acid and nicotinic acid have been reported to promote pyridoxine biosynthesis [13]. Thus, synergistic effect of Zn2+, folic acid and nicotinic acid on the colony morphological changes makes sense (Fig. 10).
Putative metabolic pathway involved in d-fructose accumulation and inhibition of biosynthesis of glycerol-3-phosphate (G3P) and d-mannitol under Zn2+ deficient condition. In this pathway, insufficient supply of Zn2+ can inhibit fructose-bisphosphate aldolase and NADPH (reduced form of NADP: nicotinamide adenine dinucleotide phosphate) dehydrogenase as it is a cofactor of both enzymes. The inhibition of the former enzyme causes smaller amount of G3P content, and that of the latter one results in d-fructose accumulation and inhibition of d-mannitol biosynthesis as insufficient Zn2+ can inhibits NADPH dehydrogenase, which leads insufficient supply of NADP, a cofactor of mannitol dehydrogenase
Putative metabolic pathway involved in l-serine accumulation. Serine sulfhydrase is shown as an example of pyridoxal phosphate enzymes. In this pathway, l-serine can be accumulated when the supply of pyridoxal-5-phosphate (P5P) is insufficient, which is caused by Zn2+ deficiency. As nicotinic acid and folic acid have been reported to promote pyridoxine biosynthesis [14], synergistic effect of Zn2+, nicotinic acid, and folic acid on colony morphology observed in present is accountable if this pathway is involved in the morphogenesis
Lanfranco et al. have reported mM order of Zn2+ increases hyphal branching and chitin production, using an ericoid fungus [14]. As another candidate of the mechanism of present phenomena, such micro scale or molecular level alternation could be considered to give toughness and wrinkled form to the colony.
These are all indirect evidence to explain present phenomena. Thus of course more experiments are necessary to conclude the mechanism, however, we believe present results will be an opportunity to discuss the fungal morphogenesis.
As T. matsutake produces valuable edible fruiting bodies, an artificial cultivation is expected. Fruiting body building is also a morphological change. Thus next our mission will be to investigate relevance of Zn2+ to fruiting using other fungi widely studied.
References
Arai Y, Takao M, Sakamoto R, Yoshikawa K, Terashita T (2003) Promotive effect of the hot water-soluble fraction from corn fiber on vegetative mycelial growth in edible mushrooms. J Wood Sci 49:437–443
Guerin-Laguette A, Vaario LM, Matsushita N, Shindo K, Suzuki K, Lapeyrie F (2003) Growth stimulation of a Shiro-like, mycorrhiza forming, mycelium of Tricholoma matsutake on solid substrates by non-ionic surfactants or vegetable oil. Mycol Prog 2(1):37–44
Kawagishi H, Hamajima K, Takanami R, Nakamura T, Sato Y, Akiyama Y, Sano M, Tanaka O (2004) Growth promotion of Mycelia of Matsutake Mushroom Tricholoma matsutake by d-isoleucine. Biosci Biotechnol Biochem 68(11):2405–2407
Vaario LM, Guerin-Laguette A, Matsushita N, Suzuki K, Lapeyrie F (2002) Saprobic potential of Tricholoma matsutake: growth over pine bark treated with surfactants. Mycorrhiza 12:1–5
Kusuda M, Ueda M, Miyatake K, Terashita T (2008) Characterization of the carbohydrase productions of an ectomycorrhizal fungus, Tricholoma matsutake. Mycoscience 49:291–297
Ogawa M (1978) Matsutake no seibutsugaku (in Japanese). Tsukiji Shokan, Japan
Geoffrey MG, Lynn R, John WG, Karl R (2001) Nutritional influence on fungal colony growth and biomass distribution in response to toxic metals. FEMS Microbiol Lett 204:311–316
Ohta A (1990) A new medium for mycelial growth of mycorrhizal fungi. Trans Mycol Soc Jpn 31:323–334
Murashige T, Skoog F (1962) A revised medium for rapid growth and bio assays with tobacco tissue cultures. Physiol Plant 15(3):473–497
Marx DH (1969) The influence of ectotrophic mycorrhizal fungi on the resistance of pathogenic infections. I. Antagonism of mycorrhizal fungi to pathogenic fungi and soil bacteria. Phytopathology 59:153–163
Talbot NJ (1997) Fungal biology: growing into the air. Curr Biol 7(2):78–81
Wessels JGH, De Vries OMH, Ásgeirsdóttir SA, Springer J (1991) The thn mutation of Schizophyllum commune, which suppresses formation of aerial hyphae, affects expression of the Sc3 hydrophobin gene. J Gen Microbiol 137:2439–2445
Vatsala TM, Shanmugasundaram KR, Shanmugasundaram ERB (1976) Role of nicotinic acid in pyridoxine biosynthesis in Aspergillus nidulans. Biochem Biophys Res Commun 72(4):1570–1575
Lanfranco L, Balsamo R, Martino E, Perotto S, Bonfante P (2002) Zinc ions alter morphology and chitin deposition in an ericoid fungus. Eur J Histochem 46:341–350
Acknowledgments
GC/MS data were acquired with equipment in the Laboratory of Systematic Forest and Forest Products Sciences in the Graduate School of Kyushu University. We’d appreciate kindness of Dr. Shimizu, an associate professor of the laboratory.
Author information
Authors and Affiliations
Corresponding author
Ethics declarations
Conflict of interest
The authors declare no conflicts of interest. All the experiments undertaken in this study comply with the current laws of the country where they were performed.
Funding
This work was supported by JSPS Grant-in-Aid for Challenging Exploratory Research Number 24658155.
Additional information
Our present work was partially presented in the 55th Annual Meeting of The Mycological Society of Japan.
Electronic supplementary material
Below is the link to the electronic supplementary material.
Rights and permissions
About this article
Cite this article
Tasaki, T., Kondo, R. Zn2+, a key factor of colony morphogenesis of Tricholoma matsutake . J Wood Sci 62, 460–471 (2016). https://doi.org/10.1007/s10086-016-1571-6
Received:
Accepted:
Published:
Issue Date:
DOI: https://doi.org/10.1007/s10086-016-1571-6